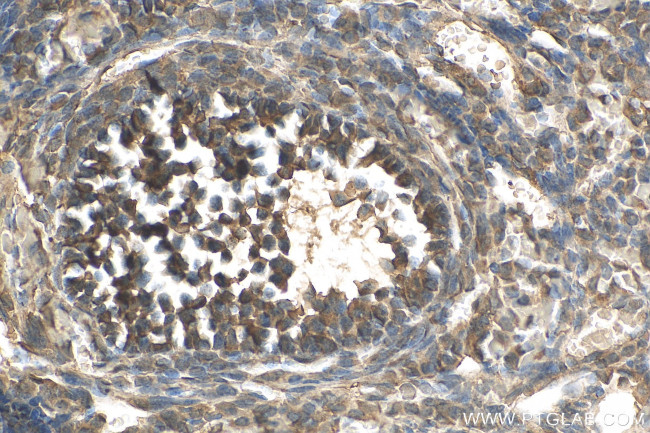
LEPREL2 Antibody in Immunohistochemistry (Paraffin) (IHC (P))

Search
Proteintech
LEPREL2 Monoclonal Antibody (1F6F3)
{{$productOrderCtrl.translations['antibody.pdp.commerceCard.promotion.promotions']}}
{{$productOrderCtrl.translations['antibody.pdp.commerceCard.promotion.viewpromo']}}
{{$productOrderCtrl.translations['antibody.pdp.commerceCard.promotion.promocode']}}: {{promo.promoCode}} {{promo.promoTitle}} {{promo.promoDescription}}. {{$productOrderCtrl.translations['antibody.pdp.commerceCard.promotion.learnmore']}}
产品信息
68299-1-IG
种属反应
宿主/亚型
分类
类型
克隆号
抗原
偶联物
形式
纯化类型
保存液
内含物
保存条件
运输条件
产品详细信息
Immunogen sequence: RALNQYQAQL GEPRPGLGPR EDIQRFILRS LGEKRQLYYA MEHLGTSFKD PDPWTPAALI PEALREKLRE DQEKRPWDHE PVKPKPLTYW KDVLLLEGVT LTQDSRQLNG SERAVLDGLL TPAECGVLLQ LAKDAAGAGA RSGYRGRRSP HTPHERFEGL TVLKAAQLAR AGTVGSQGAK LLLEVSERVR TLTQAYFSPE RPLHLSFTHL VCRSAIEGEQ EQRMDLSHPV HADNCVLDPD TGECWREPPA YTYRDYSGLL YLNDDFQGGD LFFTEPNALT VTARVRPRCG RLVAFSSGVE NPHGVWAVTR GRRCALALWH TWAPEHREQE WIEAKELLQE SQEEEEEEEE EMPSKDPSPE PPSRRHQRVQ DKTGRAPRVR EEL
靶标信息
The protein encoded by this gene belongs to the leprecan family of proteoglycans, which function as collagen prolyl hydroxylases that are required for proper collagen biosynthesis, folding and assembly. This protein, like other family members, is thought to reside in the endoplasmic reticulum. Epigenetic inactivation of this gene is associated with breast and other cancers, suggesting that it may function as a tumor suppressor.
仅用于科研。不用于诊断过程。未经明确授权不得转售。
篇参考文献 (0)
生物信息学
蛋白别名: gene rich cluster, B; leprecan-like 2; Leprecan-like protein 2; procollagen-proline 3-dioxygenase; Prolyl 3-hydroxylase 3; Protein B
基因别名: GRCB; HSU47926; LEPREL2; P3H3
UniProt ID: (Human) Q8IVL6
Entrez Gene ID: (Human) 10536, (Rat) 297595